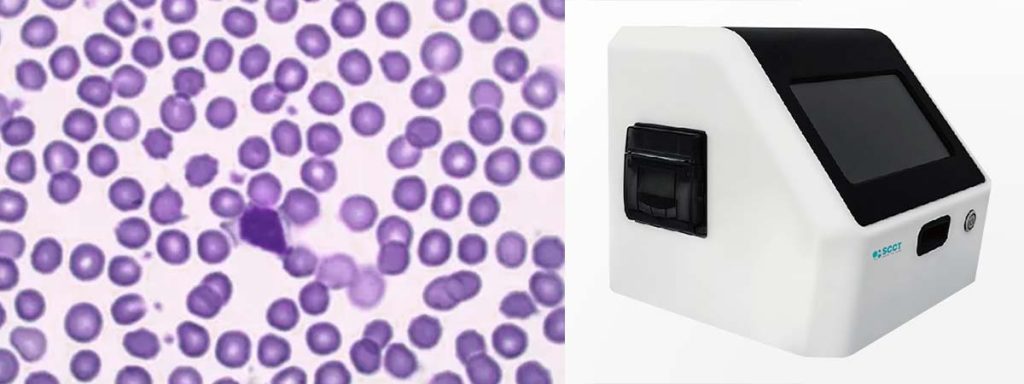
why-is-somatic-cell-count-important

An SCC tester provides instant scc results, allowing operations to see cost savings from the first test. Most facilities report a payback period between three to six months, depending on usage. For example, frequent testing can shorten ROI to under three months. Timely results help teams avoid outsourcing fees and delays, making the investment practical and measurable.
Key Takeaways
- SCC tester provides instant results, allowing dairy producers to see cost savings from the first test.
- Frequent testing can shorten the return on investment (ROI) period to under three months, maximizing savings.
- Bringing testing in-house reduces outsourcing costs, leading to significant financial benefits.
- Automating compliance tasks with SCC tester saves time and resources, enhancing overall operational efficiency.
- Dairy producers can maximize ROI by defining clear objectives and monitoring key metrics regularly.
SCC Tester Payback Factors
Testing Frequency
Testing frequency plays a major role in how quickly a dairy producer sees a return on investment from an SCC tester. Facilities that test milk quality daily or multiple times per week benefit the most. Frequent testing helps identify high scc issues early, allowing for immediate action. This reduces the risk of penalties and lost revenue due to poor milk quality. A somatic cell count tester provides instant results, so teams can make quick decisions without waiting for outsourced lab reports. When testing happens in-house, the cost per test drops, and the value of rapid feedback increases.
SCC Tester Cost Savings
An SCC tester reduces the need for outsourcing, which leads to significant cost savings. Many operations spend thousands each year sending samples to external labs. By bringing testing in-house, a dairy producer can cut these expenses almost immediately. The following table highlights features that contribute to these savings:
| Feature | Benefit |
|---|---|
| Cloud-based solutions | Reduces IT maintenance costs, minimizing the need for outsourcing. |
| Customization | Allows tailored workflows, which can lead to more efficient operations and reduced costs. |
| Rapid implementation | Deploys within 90 days, reducing setup time and associated resource costs. |
| Unlimited scalability | Supports expansion without extra overhead, increasing revenue potential without outsourcing. |
Insurance variables, such as deductibles and co-pays, also affect financial benefits. When a facility handles more testing internally, it can avoid extra charges that come with third-party services. This makes the investment in an SCC tester even more attractive.
Downtime Reduction
Downtime can be costly for any operation. Using an SCC tester helps reduce unplanned stops by providing fast, reliable data. Facilities have reported operational cost savings of up to $2 million due to less unplanned downtime. The following points show how downtime reduction translates into financial gains:
- Customers report a 40% reduction in unplanned stops, leading to more strategic maintenance focus.
- Unplanned maintenance can cost three to nine times more than planned maintenance.
- Increased uptime means equipment operates more consistently, directly contributing to financial savings.
- Improved overall equipment effectiveness (OEE) enhances performance and quality, leading to further operational savings.
A dairy producer who uses an SCC tester can focus on planned maintenance and avoid the high costs linked to emergency repairs. This approach keeps production running smoothly and protects profit margins.
Compliance Benefits
Compliance with industry standards is essential, especially for regulated sectors. An SCC tester supports compliance by automating and documenting testing processes. The table below outlines common compliance requirements addressed by SCC tester:
| Compliance Framework | Requirement | Description |
|---|---|---|
| PCI DSS | 11.4 | Conduct external and internal pen testing regularly and correct all security weaknesses and exploitable vulnerabilities. |
| CMMC | Level 2 | Requires vulnerability scanning across systems and applications for eligible organizations. |
Automating compliance tasks saves time and resources. The following table shows how these benefits contribute to overall ROI:
| Evidence Description | Impact on ROI |
|---|---|
| Automation in compliance processes saves time and resources. | Resources can be redirected towards strategic growth areas, leading to faster ROI. |
| 92% of businesses using Secureframe allocate more time to product development. | This indicates that compliance automation enhances focus on growth, contributing to revenue. |
| Compliance automation prevents costly business disruptions. | Avoiding disruptions leads to cost savings and improved operational efficiency, enhancing ROI. |
| Embracing compliance increases customer trust and security. | Higher customer trust can lead to increased sales and revenue, positively impacting ROI. |
A dairy producer who invests in compliance not only avoids fines but also builds trust with customers. This trust can lead to higher sales and a stronger reputation in the market. Addressing high SCC quickly also helps maintain compliance with milk quality standards, protecting both revenue and brand value.
ROI Calculation
Payback Formula
Calculating the return on investment for an SCC tester starts with a clear payback formula. This formula helps dairy producers understand how quickly they can recover their initial investment. The most common methods use either cash flow over time or annual cash flow. The table below summarizes the main formulas:
| Payback Period Formula | Description |
|---|---|
| Payback Period = the last year with negative cash flow + (Amount of cash flow at the end of that year / Cash flow during the year after that year) | This formula calculates the payback period based on cash flows over time. |
| Payback Period = Initial Investment ÷ Cash Flow Per Year | This formula provides a straightforward calculation of the payback period based on annual cash flow. |
| Payback Period = Initial Investment / Yearly Cash Flow | Another method to determine the payback period using yearly cash flow. |
A dairy producer can use these formulas to estimate how long it will take for the SCC tester to pay for itself. Quick calculations help teams make informed decisions about investing in milk analysis technology.
Example ROI
Consider a small dairy operation that invests $10,000 in an SCC tester. Before the purchase, the facility spends $1,000 per month on outsourced somatic cell count testing. After bringing testing in-house, the monthly cost drops to $200 for supplies and maintenance. The operation saves $800 each month.
Using the payback formula:
Payback Period = Initial Investment ÷ Cash Flow Per Year
The calculation looks like this:
- Initial Investment: $10,000
- Annual Savings: $800 x 12 = $9,600
Payback Period = $10,000 ÷ $9,600 ≈ 1.04 years
This means the operation recovers its investment in just over one year. If the facility increases testing frequency or expands herd size, the payback period shortens even further. High SCC becomes faster, and the team can act quickly to prevent high SCC milk from entering the supply chain. This protects milk quality and reduces the risk of penalties.
Key Variables
Several factors influence the ROI calculation for an SCC tester. Dairy producers should consider the following variables:
- Initial Investment: This includes tool licensing, infrastructure setup, and training costs.
- Test Case Selection: Choosing stable, high-frequency, and high-impact test cases maximizes value.
- Maintenance Effort: Frequent test failures can increase costs.
- Test Execution Speed and Frequency: Faster and more frequent tests add value.
- Team Skill and Productivity: Skilled teams achieve better results with automation.
- Time Saved: Reducing manual testing time speeds up feedback cycles.
- Defect Detection and Quality Gains: Early detection of high scc improves product quality.
- Integration with CI/CD and DevOps: Automated tests support continuous delivery.
- Reusability and Scalability: Reusable test scripts work across different platforms.
- Project Lifecycle Duration: Longer projects may see greater ROI from automation.
A dairy producer who tracks these variables can optimize the use of an SCC tester. Frequent milk analysis helps catch high SCC issues early, which keeps high-scc milk out of the market. This approach protects both revenue and reputation.
Real-World Scenarios
Small Operation Case
Small dairy operations often face unique challenges when adopting SCC tester. Manual testing of SAP changes can create hidden costs, as teams spend weeks on regression testing. Even small updates may affect many processes, which leads to incomplete coverage during manual regression cycles. Without automation, organizations must choose between thorough testing and speed. This choice can slow innovation and increase costs.
- Manual testing consumes significant time and resources
- Incomplete coverage increases risk
- Lack of automation limits growth
A small operation that invests in an SCC tester gains immediate feedback on milk quality. This rapid insight helps teams act quickly, reducing the risk of penalties and improving product consistency. Many small producers report payback periods of six to twelve months, depending on how often they test and the scale of their operation.
Large Facility Case
Large facilities benefit from SCC tester by streamlining high-volume testing. These organizations often have the resources to automate processes and train staff efficiently. They see faster ROI because they can test more frequently and at greater scale.
A large dairy may recover its investment in as little as three to six months. The ability to detect issues early and maintain high standards across multiple production lines drives these results. Teams also reduce downtime and avoid costly disruptions.
Industry Results
Across industries, several factors contribute to successful SCC tester ROI. The table below highlights common cost factors:
| Cost Factor | Description |
|---|---|
| License costs | Costs for vendor tools, including packages and agents. |
| Hardware costs | Expenses for on-premise solutions, including procurement and maintenance. |
| Training costs | Investment in training to use automation tools effectively. |
| Implementation costs | Resources for integrating and maintaining automation platforms. |
| Maintenance costs | Ongoing costs to keep test scripts updated and functional. |
Many organizations experience these benefits:
- Acceleration of agile test cycles
- Enhanced speed and efficiency of testing programs
- Improved adaptability to market demands and customer needs
A Forrester Consulting study found that a visual test automation platform delivered a 209% ROI over three years, with a payback period of just six months. This result shows that effective test automation can provide significant financial benefits and rapid returns.
Maximizing ROI
Best Practices
Dairy producers can maximize ROI from SCC tester by following proven strategies. They should define clear objectives that match business goals. This approach improves efficiency and product quality. Teams benefit from choosing scalable and flexible tools that work well with current systems. Starting with pilot projects helps identify challenges before expanding automation. Regular monitoring of key metrics allows teams to optimize ROI over time.
- Prioritize quality testing to improve software functionality, reliability, and user-friendliness.
- Invest in effective testing strategies to catch issues early and reduce costly rework.
- Focus on delivering high-quality products to gain a competitive edge.
A milk quality app can further enhance results by providing real-time data and actionable insights. On-farm milk analysis enables teams to make quick decisions, reducing reliance on traditional testing methods and speeding up payback.
Tip: Teams that monitor both financial and non-financial factors gain a complete view of project success. They should use metrics like NPV and IRR, not just payback period, to evaluate profitability and risk.
Common Mistakes
Some organizations make mistakes that delay ROI from SCC tester. They may focus on too many benefits, which can seem unrealistic. Highlighting a few credible advantages strengthens the business case. Many companies miscalculate ROI by using the wrong formula. The correct calculation divides the average net benefit during the first three years by the initial investment. Teams should also highlight the payback period, as this reduces perceived risk and makes the investment more appealing.
- Ignoring the time value of money can lead to poor project comparisons.
- Relying only on payback period without considering other metrics may hide risks.
- Failing to align payback criteria with company goals can cause missed opportunities.
- Overlooking non-financial factors may result in incomplete evaluations.
By avoiding these mistakes, dairy producers can ensure faster and more reliable returns from their SCC tester investments.
Conclusion

An SCC tester delivers rapid ROI through instant results and significant cost savings. Many facilities report cost reductions of up to 85% and annual savings exceeding $250,000. The table below highlights key ROI metrics:
| Metric | Value |
|---|---|
| Cost Reduction | 85% |
| Speed Improvement | 10x |
| Annual Savings | $250,000+ |
Companies should review their current testing costs and use ROI calculators or sales intelligence tools to estimate potential returns. They can contact suppliers for tailored ROI strategies and personalized insights.
FAQ
How Quickly Can Teams See ROI from an SCC Tester?
Most teams see ROI within three to six months. High testing frequency and in-house analysis speed up payback. Instant results help reduce costs and improve decision-making.
What Ongoing Costs Should Users Expect?
Users should budget for supplies, maintenance, and occasional calibration. These costs remain much lower than outsourcing fees. Most facilities report predictable monthly expenses.
Does an SCC Tester Improve Milk Quality Compliance?
Yes. SCC tester provides fast, accurate results. Teams can address high somatic cell counts before milk leaves the facility. This helps maintain compliance and avoid penalties.
Can Small Operations Benefit from SCC Testers?
Small operations gain value by reducing outsourcing and improving milk quality. Quick feedback allows for faster action. Many small producers report payback within a year.
What Training Is Needed to Use an SCC Tester?
Most SCC testers feature user-friendly interfaces. Basic training covers sample preparation and device operation. Teams usually become proficient within a few days.